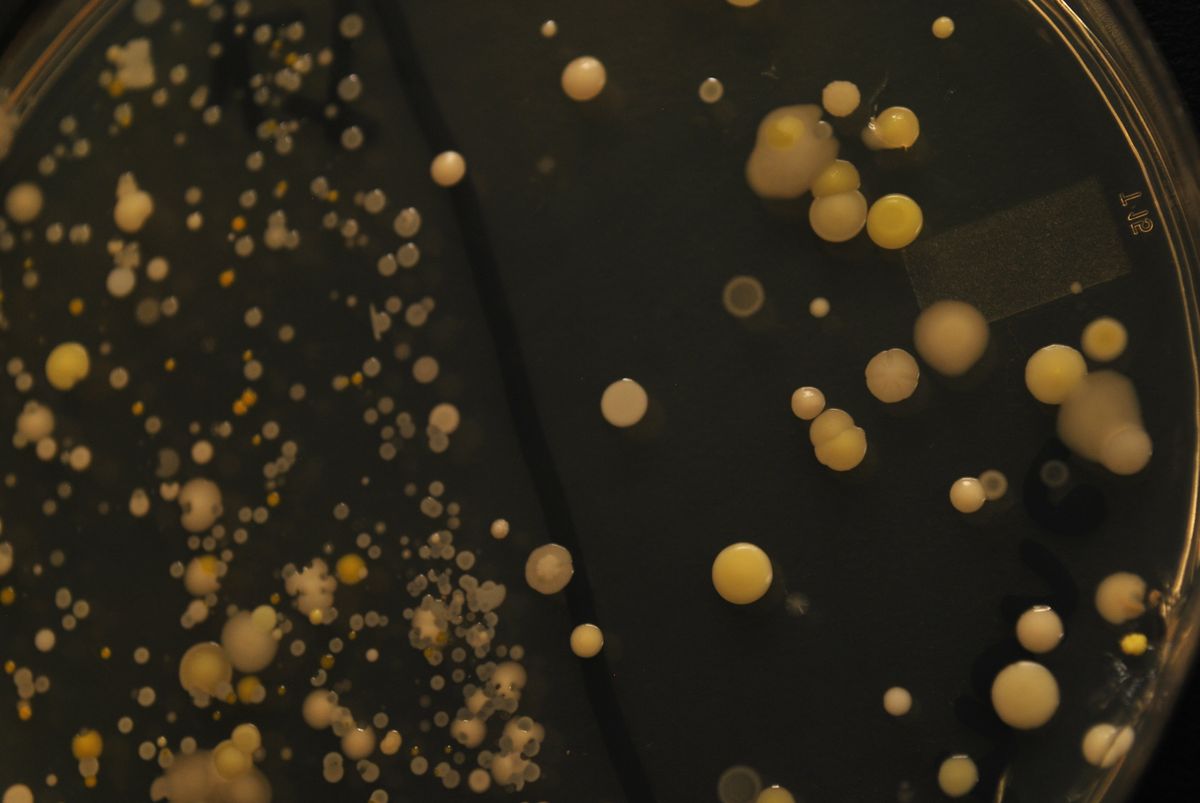

Food Science Toolbox
209 sostenitori
Bacteria colonies on nutrient agar - Before and after handwashing
$10
25 la gente l'ha comprato
undefined
$10
25 la gente l'ha comprato
Inserisci un prezzo equo
$
Gratuito per i membri
Diventa membro per ottenere uno sconto e altri vantaggi esclusivi.
$10